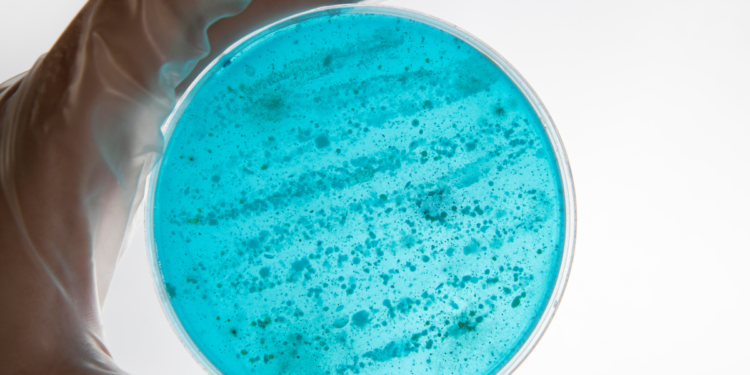
Alerta no Brasil: uma das piores superbactérias do mundo já foi identificada no país

Um caso registrado no Brasil acendeu o alerta para a presença de uma das superbactérias mais perigosas do mundo em ambiente hospitalar.
Um bebê extremamente prematuro morreu após infecção em uma UTI neonatal de Porto Alegre, onde outros três recém-nascidos também testaram positivo para o mesmo microrganismo.
Superbactéria resistente preocupa autoridades de saúde
A infecção foi causada pela bactéria Acinetobacter baumannii, considerada pela Organização Mundial da Saúde (OMS) uma das mais críticas ameaças à saúde global. O microrganismo é classificado como pan-resistente — ou seja, não responde aos antibióticos disponíveis atualmente, o que dificulta significativamente o tratamento.
Esse tipo de bactéria costuma se espalhar em ambientes hospitalares, principalmente em unidades de terapia intensiva, onde há pacientes mais vulneráveis, como recém-nascidos prematuros. Segundo especialistas, o risco aumenta conforme o tempo de internação e o uso de antibióticos de amplo espectro.
Diante da identificação dos casos, o hospital adotou medidas rigorosas de contenção. A área foi isolada, novas internações foram suspensas e todos os pacientes passaram por testagem. Ao todo, 34 bebês estavam internados na unidade no momento da detecção.
As autoridades de saúde também foram acionadas. A Secretaria Municipal de Saúde informou que gestantes de alto risco estão sendo redirecionadas para outras maternidades, como forma de evitar novos casos e garantir a continuidade do atendimento.
A preocupação com a Acinetobacter baumannii não é recente. A OMS já destacou que bactérias com esse perfil representam um dos maiores desafios da medicina moderna, especialmente devido ao uso excessivo e inadequado de antibióticos, que contribui para o avanço da resistência.
Apesar do cenário de alerta, os outros bebês infectados seguem estáveis e sob monitoramento intensivo. O caso reforça a importância de protocolos rígidos de controle de infecção hospitalar e vigilância constante para evitar a disseminação dessas superbactérias.